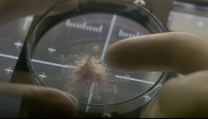

Passengers, due speciali backstage e un nuovo spot dello sci-fi con Jennifer Lawrence e Chris Pratt in uscita al cinema il 30 dicembre
24 Nov 2016
21 Nov 2016

Attraction: terzo trailer per lo sci-fi russo atteso con curiosità
19 Nov 2016

Before I Fall: rilasciato il trailer ufficiale del film con Zoey Deutch, Halston Sage e Jennifer Beals
11 Nov 2016

Contatti alieni, i 10 titoli di fantascienza indimenticabili nella storia del cinema in un video
10 Nov 2016

"Valerian e la città dei mille pianeti": il teaser trailer del film di Luc Besson con Dane DeHaan, Cara Delevingne, Clive Owen, Ethan Hawke, Rutger Hauer...
09 Nov 2016

Arrival, due nuove clip backstage del film sci-fi di Denis Villeneuve, in uscita al cinema il 17 gennaio 2017
31 Ott 2016
Nuovo trailer per il thriller fantascientifico di Daniel Espinosa con Jake Gyllenhaal e Rebecca Ferguson
23 Ott 2016

Il primo capitolo di "Valerian e la Città dei Mille Pianeti" uscirà nelle sale solamente a luglio, ma Besson non vede già l'ora di girare il sequel, e st...
18 Ott 2016

Aaron Paul entra nel cast dello sci-fi thriller Android insieme a Olga Kurylenko
Pagine

Per condividere o scaricare questo video: TV Animalista